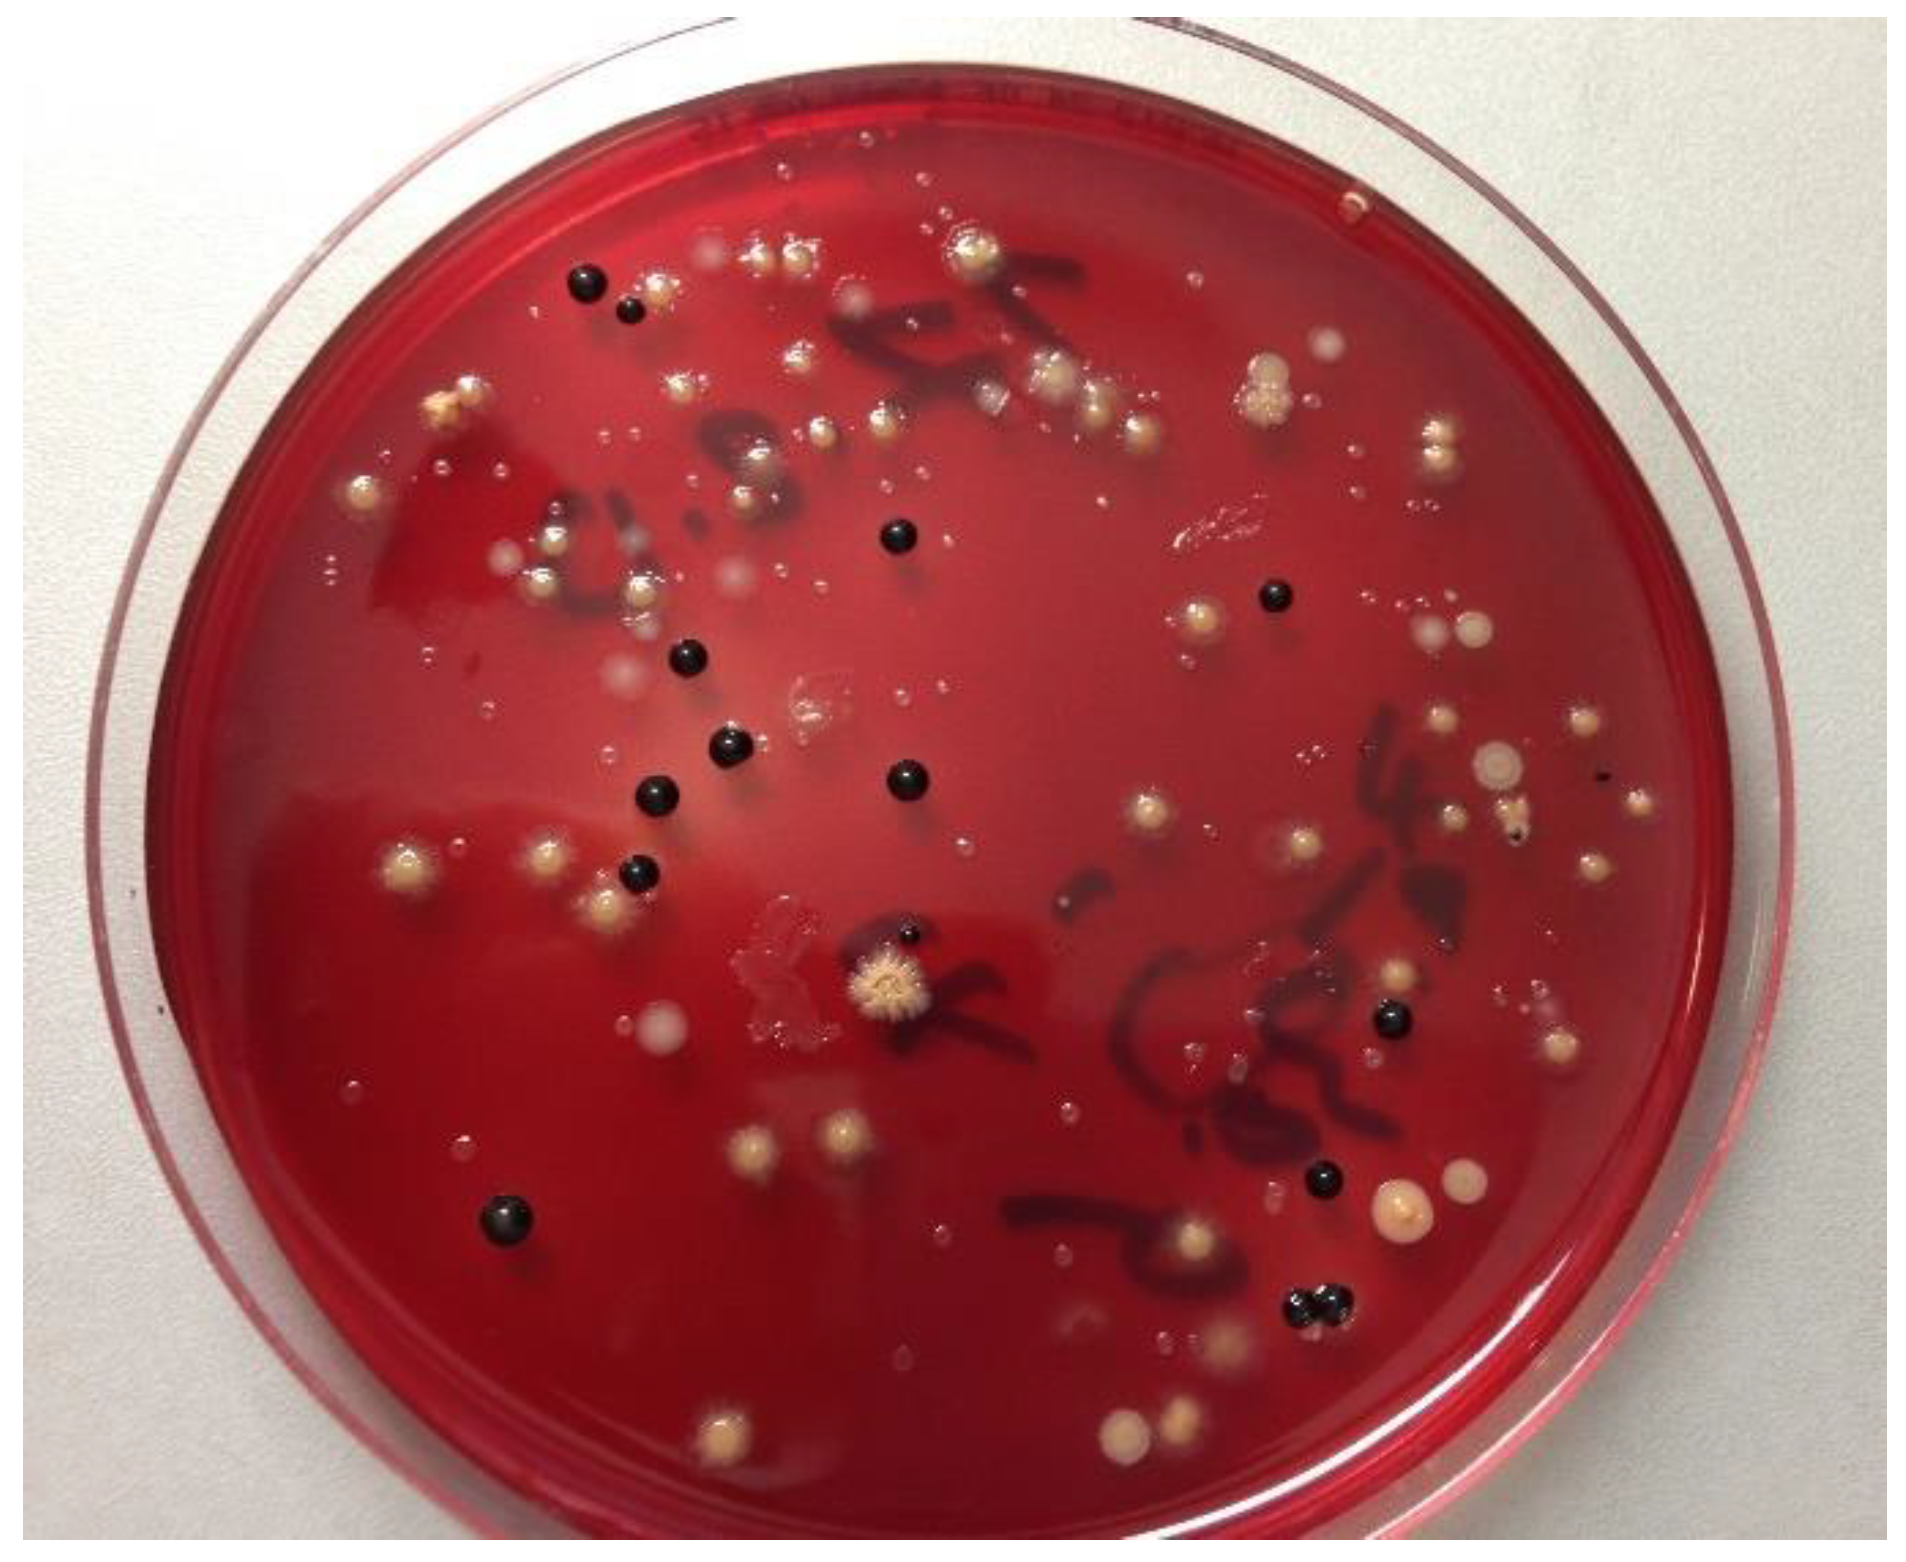
Antibiotics 10 00481 g001

Long-Term Use of Oral Hygiene Products Containing Stannous and Fluoride Ions: Effect on Viable Salivary Bacteria
Abstract
1. Introduction
2. Materials and Methods
2.1. Study Design
2.2. Participants
2.3. Intervention
2.4. Clinical and Microbiological Examination
2.5. Collection and Storage of Samples
2.6. Isolation and Identification of Bacterial Species
2.7. Blinding and Randomization
2.8. Statistical Analysis
3. Results
3.1. Demographic Data
3.2. Summary of Clinical Parameters
3.3. Microbiological Data
3.3.1. Total Bacterial Counts
3.3.2. Microbial Composition
4. Discussion
5. Conclusions
Supplementary Materials
Author Contributions
Funding
Institutional Review Board Statement
Informed Consent Statement
Data Availability Statement
Acknowledgments
Conflicts of Interest
References
- Buzalaf, M.A.R.; Pessan, J.P.; Honório, H.M.; ten Cate, J.M. Mechanisms of Action of Fluoride for Caries Control. In Monographs in Oral Science; Buzalaf, M.A.R., Ed.; KARGER: Basel, Switzerland, 2011; Volume 22, pp. 97–114. ISBN 978-3-8055-9659-6. [Google Scholar]
- Imfeld, T.; Sener, B.; Kuytz, C.; Brodowski, D. Mechanische Und Chemische Wirkung Einer Neuen Zinnfluorid-Zahnpaste Auf Dentin. Acta Med. Dent. Helv. 1999, 4, 107–114. [Google Scholar]
- Schlueter, N.; Hardt, M.; Lussi, A.; Engelmann, F.; Klimek, J.; Ganss, C. Tin-Containing Fluoride Solutions as Anti-Erosive Agents in Enamel: An in vitro Tin-Uptake, Tissue-Loss, and Scanning Electron Micrograph Study. Eur. J. Oral Sci. 2009, 117, 427–434. [Google Scholar] [CrossRef] [PubMed]
- Ganss, C.; Neutard, L.; von Hinckeldey, J.; Klimek, J.; Schlueter, N. Efficacy of a Tin/Fluoride Rinse: A Randomized in Situ Trial on Erosion. J. Dent. Res. 2010, 89, 1214–1218. [Google Scholar] [CrossRef] [PubMed]
- Marsh, P.; Martin, M. Chapter 5: Dental plaque. In Marsh and Martin’s Oral Microbiology; Elsevier: Edinburgh, UK; New York, NY, USA, 2016; pp. 81–111. [Google Scholar]
- Miller, S.; Truong, T.; Heu, R.; Stranick, M.; Bouchard, D.; Gaffar, A. Recent Advances in Stannous Fluoride Technology: Antibacterial Efficacy and Mechanism of Action towards Hypersensitivity. Int. Dent. J. 1994, 44, 83–98. [Google Scholar]
- Lussi, A.; Carvalho, T.S. The Future of Fluorides and Other Protective Agents in Erosion Prevention. CRE 2015, 49, 18–29. [Google Scholar] [CrossRef]
- Addy, M.; Greenman, J.; Renton-Harper, P.; Newcombe, R.; Doherty, F. Studies on Stannous Fluoride Toothpaste and Gel (2). Effects on Salivary Bacterial Counts and Plaque Regrowth in Vivo. J. Clin. Periodontol. 1997, 24, 86–91. [Google Scholar] [CrossRef] [PubMed]
- Cheng, X.; Liu, J.; Li, J.; Zhou, X.; Wang, L.; Liu, J.; Xu, X. Comparative Effect of a Stannous Fluoride Toothpaste and a Sodium Fluoride Toothpaste on a Multispecies Biofilm. Arch. Oral Biol. 2017, 74, 5–11. [Google Scholar] [CrossRef] [PubMed]
- Sultan, A.S.; Kong, E.F.; Rizk, A.M.; Jabra-Rizk, M.A. The Oral Microbiome: A Lesson in Coexistence. PLoS Pathog. 2018, 14, e1006719. [Google Scholar] [CrossRef]
- Anderson, A.C.; Rothballer, M.; Altenburger, M.J.; Woelber, J.P.; Karygianni, L.; Lagkouvardos, I.; Hellwig, E.; Al-Ahmad, A. In-Vivo Shift of the Microbiota in Oral Biofilm in Response to Frequent Sucrose Consumption. Sci. Rep. 2018, 8, 14202. [Google Scholar] [CrossRef]
- Belstrøm, D.; Constancias, F.; Liu, Y.; Yang, L.; Drautz-Moses, D.I.; Schuster, S.C.; Kohli, G.S.; Jakobsen, T.H.; Holmstrup, P.; Givskov, M. Metagenomic and Metatranscriptomic Analysis of Saliva Reveals Disease-Associated Microbiota in Patients with Periodontitis and Dental Caries. NPJ Biofilms Microb. 2017, 3, 23. [Google Scholar] [CrossRef]
- Frese, C.; Wohlrab, T.; Sheng, L.; Kieser, M.; Krisam, J.; Frese, F.; Wolff, D. Clinical Management and Prevention of Dental Caries in Athletes: A Four-Year Randomized Controlled Clinical Trial. Sci. Rep. 2018, 8, 1–10. [Google Scholar] [CrossRef]
- Anderson, A.C.; Al-Ahmad, A.; Schlueter, N.; Frese, C.; Hellwig, E.; Binder, N. Influence of the Long-Term Use of Oral Hygiene Products Containing Stannous Ions on the Salivary Microbiome—A Randomized Controlled Trial. Sci. Rep. 2020, 10, 9546. [Google Scholar] [CrossRef]
- Schulz, K.F.; Altman, D.G.; Moher, D.; CONSORT Group. CONSORT 2010 Statement: Updated Guidelines for Reporting Parallel Group Randomised Trials. Int. J. Surg. 2011, 9, 672–677. [Google Scholar] [CrossRef]
- Bartlett, D.; Ganss, C.; Lussi, A. Basic Erosive Wear Examination (BEWE): A New Scoring System for Scientific and Clinical Needs. Clin. Oral Investig. 2008, 12, 65–68. [Google Scholar] [CrossRef] [PubMed]
- Braga, M.M.; Oliveira, L.B.; Bonini, G.A.V.C.; Bönecker, M.; Mendes, F.M. Feasibility of the International Caries Detection and Assessment System (ICDAS-II) in Epidemiological Surveys and Comparability with Standard World Health Organization Criteria. Caries Res. 2009, 43, 245–249. [Google Scholar] [CrossRef]
- Downes, J.; Hooper, S.J.; Wilson, M.J.; Wade, W.G. Prevotella Histicola Sp. Nov., Isolated from the Human Oral Cavity. Int. J. Syst. Evol. Microbiol. 2008, 58, 1788–1791. [Google Scholar] [CrossRef] [PubMed]
- Zhang, Y.; Zhen, M.; Zhan, Y.; Song, Y.; Zhang, Q.; Wang, J. Population-Genomic Insights into Variation in Prevotella Intermedia and Prevotella Nigrescens Isolates and Its Association with Periodontal Disease. Front. Cell. Infect. Microbiol. 2017, 7, 409. [Google Scholar] [CrossRef]
- Socransky, S.S.; Haffajee, A.D.; Cugini, M.A.; Smith, C.; Kent, R.L., Jr. Microbial Complexes in Subgingival Plaque. J. Clin. Periodontol. 1998, 25, 134–144. [Google Scholar] [CrossRef] [PubMed]
- Wang, Y.; Zhang, J.; Chen, X.; Jiang, W.; Wang, S.; Xu, L.; Tu, Y.; Zheng, P.; Wang, Y.; Lin, X.; et al. Profiling of Oral Microbiota in Early Childhood Caries Using Single-Molecule Real-Time Sequencing. Front. Microbiol. 2017, 8, 2244. [Google Scholar] [CrossRef]
- Yang, F.; Zeng, X.; Ning, K.; Liu, K.-L.; Lo, C.-C.; Wang, W.; Chen, J.; Wang, D.; Huang, R.; Chang, X.; et al. Saliva Microbiomes Distinguish Caries-Active from Healthy Human Populations. ISME J. 2012, 6, 1–10. [Google Scholar] [CrossRef] [PubMed]
- Zaura, E.; Brandt, B.W.; Prodan, A.; Teixeira de Mattos, M.J.; Imangaliyev, S.; Kool, J.; Buijs, M.J.; Jagers, F.L.; Hennequin-Hoenderdos, N.L.; Slot, D.E.; et al. On the Ecosystemic Network of Saliva in Healthy Young Adults. ISME J. 2017, 11, 1218–1231. [Google Scholar] [CrossRef]
- Shapiro, S.; Giertsen, E.; Guggenheim, B. An in Vitro Oral Biofilm Model for Comparing the Efficacy of Antimicrobial Mouthrinses. CRE 2002, 36, 93–100. [Google Scholar] [CrossRef]
- Arweiler, N.B.; Netuschil, L.; Reich, E. Alcohol-Free Mouthrinse Solutions to Reduce Supragingival Plaque Regrowth and Vitality. A Controlled Clinical Study. J. Clin. Periodontol. 2001, 28, 168–174. [Google Scholar] [CrossRef]
- Auschill, T.M.; Hein, N.; Hellwig, E.; Follo, M.; Sculean, A.; Arweiler, N.B. Effect of Two Antimicrobial Agents on Early in Situ Biofilm Formation. J. Clin. Periodontol. 2005, 32, 147–152. [Google Scholar] [CrossRef]
- Shapira, L.; Shapira, M.; Tandlich, M.; Gedalia, I. Effect of Amine Fluoride-Stannous Fluoride Containing Toothpaste (Meridol) on Plaque and Gingivitis in Adults: A Six-Month Clinical Study. J. Int. Acad Periodontol. 1999, 1, 117–120. [Google Scholar] [PubMed]
- Schöffel, N.; Braun, M.; Bendels, M.H.K.; Groneberg, D.A. Aktinomykose—Humane Infektion mit Aktinomyzeten: Eine Literaturübersicht. Zent. für Arb. Arb. und Ergon. 2018, 68, 338–340. [Google Scholar] [CrossRef]
- Marsh, P.; Martin, M.V. Orale Mikrobiologie: 60 Tabellen; Thieme: Stuttgart, Germany, 2003; ISBN 978-3-13-129731-0. [Google Scholar]
- Kneist, S.; Sieckmann, C.; Küpper, H. Zur antimikrobiellen Wirkung von NaF-haltigen Zahnpasten. ZWR 2012, 121, 78–88. [Google Scholar] [CrossRef]
- Bowden, G.H.W. Microbiology of Root Surface Caries in Humans. J. Dent. Res. 1990, 69, 1205–1210. [Google Scholar] [CrossRef]
- Weerkamp, A.H.; McBride, B.C. Characterization of the Adherence Properties of Streptococcus Salivarius. Infect. Immun. 1980, 29, 459–468. [Google Scholar]
- Byun, R.; Carlier, J.-P.; Jacques, N.A.; Marchandin, H.; Hunter, N. Veillonella Denticariosi Sp. Nov., Isolated from Human Carious Dentine. Int. J. Syst. Evol. Microbiol. 2007, 57, 2844–2848. [Google Scholar] [CrossRef] [PubMed]
- Van Houte, J.; Gibbons, R.J.; Pulkkinen, A.J. Ecology of Human Oral Lactobacilli. Infect. Immun. 1972, 6, 723–729. [Google Scholar] [CrossRef] [PubMed]
- Belstrøm, D. The Salivary Microbiota in Health and Disease. J. Oral Microbiol. 2020, 12, 1723975. [Google Scholar] [CrossRef]
- Paster, B.J.; Boches, S.K.; Galvin, J.L.; Ericson, R.E.; Lau, C.N.; Levanos, V.A.; Sahasrabudhe, A.; Dewhirst, F.E. Bacterial Diversity in Human Subgingival Plaque. J. Bacteriol. 2001, 183, 3770–3783. [Google Scholar] [CrossRef] [PubMed]
- Anderson, A.C.; Hellwig, E.; Vespermann, R.; Wittmer, A.; Schmid, M.; Karygianni, L.; Al-Ahmad, A. Comprehensive Analysis of Secondary Dental Root Canal Infections: A Combination of Culture and Culture-Independent Approaches Reveals New Insights. PLoS ONE 2012, 7, e49576. [Google Scholar] [CrossRef]
- Hannig, C.; Hannig, M.; Rehmer, O.; Braun, G.; Hellwig, E.; Al-Ahmad, A. Fluorescence Microscopic Visualization and Quantification of Initial Bacterial Colonization on Enamel in Situ. Arch. Oral Biol. 2007, 52, 1048–1056. [Google Scholar] [CrossRef] [PubMed]
- Sinha, R.; Abu-Ali, G.; Vogtmann, E.; Fodor, A.A.; Ren, B.; Amir, A.; Schwager, E.; Crabtree, J.; Ma, S.; Microbiome Quality Control Project Consortium; et al. Assessment of Variation in Microbial Community Amplicon Sequencing by the Microbiome Quality Control (MBQC) Project Consortium. Nat. Biotechnol. 2017, 35, 1077–1086. [Google Scholar] [CrossRef] [PubMed]
- Manoil, D.; Al-Manei, K.; Belibasakis, G.N. A Systematic Review of the Root Canal Microbiota Associated with Apical Periodontitis: Lessons from Next-Generation Sequencing. Proteom. Clin. Appl. 2020, 14, e1900060. [Google Scholar] [CrossRef] [PubMed]
- Mark Welch, J.L.; Rossetti, B.J.; Rieken, C.W.; Dewhirst, F.E.; Borisy, G.G. Biogeography of a Human Oral Microbiome at the Micron Scale. Proc. Natl. Acad. Sci. USA 2016, 113, E791–E800. [Google Scholar] [CrossRef] [PubMed]
- Luo, T.; Srinivasan, U.; Ramadugu, K.; Shedden, K.A.; Neiswanger, K.; Trumble, E.; Li, J.J.; McNeil, D.W.; Crout, R.J.; Weyant, R.J.; et al. Effects of Specimen Collection Methodologies and Storage Conditions on the Short-Term Stability of Oral Microbiome Taxonomy. Appl. Environ. Microbiol. 2016, 82, 5519–5529. [Google Scholar] [CrossRef]
- Schlueter, N.; Tveit, A.B. Prevalence of Erosive Tooth Wear in Risk Groups. Monogr. Oral Sci. 2014, 25, 74–98. [Google Scholar] [CrossRef]

| Participants (n = 32) | Test Group (n = 16) | Control Group (n = 16) |
|---|---|---|
| Age | 35.8 ± 10.8 | 34.9 ± 8.52 |
| Gender | 12 (75%) male 4 (25%) female | 15 (94%) male 1 (6%) female |
Publisher’s Note: MDPI stays neutral with regard to jurisdictional claims in published maps and institutional affiliations. |
© 2021 by the authors. Licensee MDPI, Basel, Switzerland. This article is an open access article distributed under the terms and conditions of the Creative Commons Attribution (CC BY) license (https://creativecommons.org/licenses/by/4.0/).
Share and Cite
Kruse, A.B.; Schlueter, N.; Kortmann, V.K.; Frese, C.; Anderson, A.; Wittmer, A.; Hellwig, E.; Vach, K.; Al-Ahmad, A. Long-Term Use of Oral Hygiene Products Containing Stannous and Fluoride Ions: Effect on Viable Salivary Bacteria. Antibiotics 2021, 10, 481. https://doi.org/10.3390/antibiotics10050481
Kruse AB, Schlueter N, Kortmann VK, Frese C, Anderson A, Wittmer A, Hellwig E, Vach K, Al-Ahmad A. Long-Term Use of Oral Hygiene Products Containing Stannous and Fluoride Ions: Effect on Viable Salivary Bacteria. Antibiotics. 2021; 10(5):481. https://doi.org/10.3390/antibiotics10050481
Chicago/Turabian StyleKruse, Anne Brigitte, Nadine Schlueter, Viktoria Konstanze Kortmann, Cornelia Frese, Annette Anderson, Annette Wittmer, Elmar Hellwig, Kirstin Vach, and Ali Al-Ahmad. 2021. "Long-Term Use of Oral Hygiene Products Containing Stannous and Fluoride Ions: Effect on Viable Salivary Bacteria" Antibiotics 10, no. 5: 481. https://doi.org/10.3390/antibiotics10050481
APA StyleKruse, A. B., Schlueter, N., Kortmann, V. K., Frese, C., Anderson, A., Wittmer, A., Hellwig, E., Vach, K., & Al-Ahmad, A. (2021). Long-Term Use of Oral Hygiene Products Containing Stannous and Fluoride Ions: Effect on Viable Salivary Bacteria. Antibiotics, 10(5), 481. https://doi.org/10.3390/antibiotics10050481

